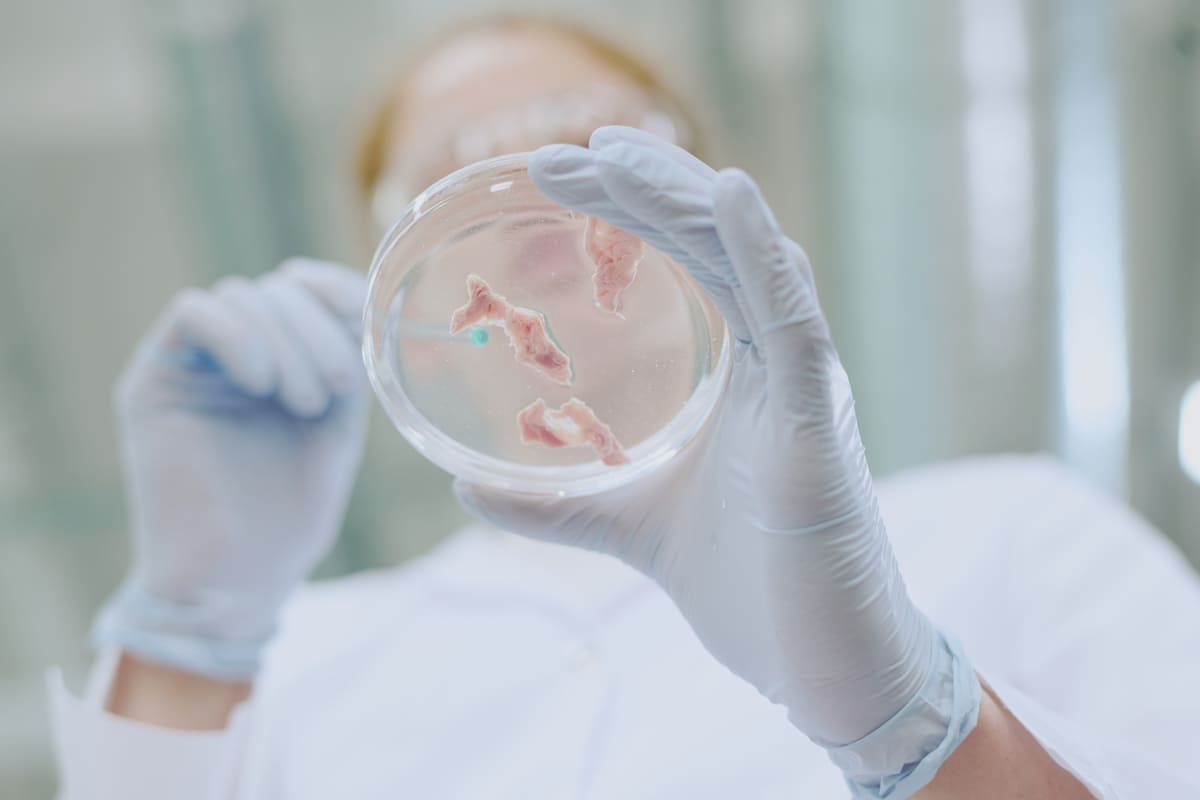

İkincil İnfertilite Hakkında Bilmeniz Gerekenler
Daha önce gebelik yaşandıysa neden yeniden zorlaşabilir? İkincil infertilitenin nedenleri, belirtileri ve tedavi yollarını keşfedin.
Sekonder infertilite, daha önce en az bir gebelik elde edilmiş olmasına rağmen yeniden gebelik oluşmaması durumudur. Bazı kaynaklar bu tanımı, önceki tedavisiz canlı doğum öyküsü üzerinden daha dar biçimde ele alır. Sekonder infertilitenin sıklığı, kullanılan tanıma ve incelenen topluma göre değişebilir.
Peki, ikincil kısırlık neden olur? Kadınlarda ve erkeklerde hangi faktörler etkili olabilir? Tedavi seçenekleri nelerdir? Bu yazımda ikincil infertilite hakkında bilgi bulabilirsiniz.
İkincil Kısırlık Nedir?

Cleveland Clinic ikincil infertiliteyi şöyle tanımlar: İkincil infertilite, daha önce kendiliğinden gerçekleşmiş bir gebelik ve canlı doğum öyküsü bulunan çiftlerin, sonrasında yeniden gebelik elde edememesi ya da oluşan gebeliğin canlı doğuma ulaşamaması durumudur.
Bazı kaynaklar ikincil infertilite tanımını, önceki gebeliğin yardımcı üreme yöntemleri kullanılmadan gerçekleşmiş olması üzerinden daha dar biçimde ele alır.
Daha önce doğal yollarla gebelik elde etmiş bir çiftin düzenli ve korunmasız cinsel ilişkiye rağmen bir yıl boyunca gebelik elde edememesi durumunda ikincil kısırlık tanısı gündeme gelir.
35 yaş ve üzerindeki kadınlarda yumurtalık rezervi ve yumurta kalitesi hızla azalma eğiliminde olduğundan bu süre altı aya düşer. 40 yaş üzerinde zaman kaybetmeden değerlendirilme yapılması önerilir.
WebMD’ye göre, ikincil kısırlık hem kadın hem de erkek kaynaklı faktörlerden kaynaklanabilir. Kadınlarda yumurtlama düzensizlikleri, tüp tıkanıklıkları veya hormonal bozukluklar kısırlık nedenleri arasında yer alırken erkeklerde ise sperm kalitesinin düşmesi, düşük testosteron seviyeleri veya geçirilmiş enfeksiyonlar önemli rol oynayabilir.
İkincil Kısırlığın Nedenleri Nelerdir?
İlk hamilelik süreci sorunsuz geçmiş olabilir. Fakat vücutta zamanla meydana gelen değişiklikler, doğum sonrası komplikasyonlar veya hormonal dengesizlikler ikinci kez çocuk sahibi olmayı zorlaştırabilir.
Kadınlarda İkincil Kısırlık Nedenleri:
- Yaş ilerledikçe yumurtalık rezervi azalır ve yumurta kalitesi düşer. Bu durum doğal yolla gebeliğin gerçekleşmesini zorlaştırır. Detaylı bilgiyi ilgili blog yazımda bulabilirsiniz.
- Rahmin iç tabakasını oluşturan endometrium benzeri dokunun rahim dışında büyümesiyle ortaya çıkan endometriozis, üreme sisteminde yapışıklıklar ve anatomik ya da işlevsel sorunlarla ilişkilendirilebilir.
- Fallop tüpleri, döllenmiş yumurtanın rahme ulaşmasını sağlayan kanallardır. Geçirilmiş enfeksiyonlar, pelvik inflamatuar hastalık (PID) veya önceki sezaryen gibi cerrahi işlemler bu tüplerde tıkanmaya yol açabilir.
- Polikistik over sendromu, yumurtalıkların düzgün çalışmasını engelleyen hormonal bir hastalıktır. PCOS’lu kadınlarda düzensiz yumurtlama veya hiç yumurtlama olmaması nedeniyle hamile kalmak zorlaşabilir.
- Fazla kilo, hormonal dengesizliklere yol açarak yumurtlamayı bozabilir.
Erkeklerde İkincil Kısırlık Nedenleri:
- Yaş ilerledikçe sperm kalitesi ve hareketliliği azalabilir.
- Testosteron, sperm üretimi için hayati öneme sahiptir. Testosteron seviyesinin bir nedenle düşmesi sperm üretim mekanizmasına zarar verebilir.
- Bazı durumlarda prostat ameliyatı sonrası meninin mesaneye geri kaçması (retrograd ejakülasyon) görülebilir, bu da doğal yolla gebeliği engelleyebilir.
- Varikosel hastalığı erkeklerde ikincil infertilite nedenleri arasında yer alabilir.
Tüm bunlara ek olarak fazla kilo erkeklerde de tıpkı kadınlarda olduğu gibi ikincil infertiliteye yol açabilir. Bunun temel nedeni fazla kilonun, östrojen seviyelerini artırarak testosteron seviyesini düşürebilmesi ve sperm üretimini olumsuz etkileyebilmesidir.
İkincil Kısırlığın Belirtileri Nelerdir?

İkincil kısırlığın en önemli belirtisi, düzenli ve korunmasız cinsel ilişkiye rağmen gebelik elde edilememesidir.
Penn Medicine kaynağında ikincil infertilitenin diğer olası belirtileri şu şekilde sıralanır:
- Kadınlarda düzensiz âdet döngüsü veya âdet görememe
- Tekrarlayan düşükler
- Aşırı kıllanma veya saç dökülmesi
- Pelvik inflamatuar hastalık
İkincil Kısırlık İçin Tedavi Yöntemleri Nelerdir?

İkincil kısırlık yaşayan çiftler için tedavi seçenekleri, altta yatan nedene göre belirlenir.
Kadınlar İçin Tedavi Seçenekleri
İkincil kısırlık yaşayan kadınlar için uygulanabilecek tedavi seçenekleri, altta yatan sağlık durumuna göre değişiklik gösterir. İlk olarak, düzenli yumurtlama sürecini desteklemeye yönelik tedaviler tercih edilebilir. Bu tür tedaviler, özellikle yumurtlama düzensizlikleri veya polikistik over sendromu (PCOS) gibi durumları olan kadınlar için etkili olabilir.
Bazen gebeliğin oluşmasını engelleyen, yapısal problemlerdir. Miyomlar, polipler veya rahim içi yapışıklıklar gibi durumlar, döllenmiş yumurtanın rahme tutunmasını zorlaştırabilir. Yapılan testler sonucunda bu tür bir sorun tespit edilirse cerrahi müdahale ile rahmin sağlıklı yapısının korunması ve gebelik ihtimalinin artırılması hedeflenebilir. Fallop tüplerinde tıkanıklık olan hastalarda da benzer şekilde cerrahi tedaviler uygulanabilir.
Doğal yollarla gebelik elde edemeyen veya ileri yaş nedeniyle yumurtalık rezervi azalmış kadınlar için yardımcı üreme teknikleri değerlendirilir. Bu yöntemler arasında en yaygın kullanılanlardan biri tüp bebek tedavisidir. Tüp bebek tedavisi özellikle fallop tüplerinde tıkanıklık, yumurta rezervi düşüklüğü veya açıklanamayan kısırlık sorunu yaşayan çiftlerde etkili seçeneklerden biri olarak görülmektedir.
Bireysel faktörlere bağlı olarak her hastaya özel bir tedavi planı oluşturulmalı ve bu süreç uzman doktor kontrolünde yürütülmelidir. Tedavinin başarısı; kişinin yaşı, yumurta kalitesi, genel sağlık durumu ve uygulanan yönteme bağlı olarak değişiklik gösterebilir.
Erkekler İçin Tedavi Seçenekleri
İkincil kısırlık yaşayan erkekler için tedavi süreci, sorunun kaynağını belirlemeye yönelik bir değerlendirme ile başlar. Bu noktada sperm kalitesi, hareketliliği ve sayısındaki değişikliklerin yanı sıra hormonal dengesizliklerin de detaylı bir şekilde incelenmesi önemlidir. Altta yatan nedene bağlı olarak şu tedavi seçenekleri uygulanabilir:
Dünya Sağlık Örgütüne göre, sigara, alkol ve sağlıksız beslenme sperm kalitesini düşüren önemli faktörlerden bazılarıdır. Dahası stres ve yaşam tarzı ile ilgili seçimler de sperm kalitesinde belirleyici olabilir. Yapılan tetkiklerin sonuçları göz önünde bulundurarak yaşam tarzının değiştirilmesi gereklilik hâline gelebilir.
Aşılama, özellikle sperm hareketliliği düşük veya ejakülasyonla ilgili sorunları olan erkeklerde tercih edilen bir yöntemdir. Bu işlemde laboratuvar ortamında hazırlanan sperm hücreleri, doğrudan rahim içine enjekte edilir.
Erkeklerde kısırlık nedenlerinden biri olan varikosel, testislerdeki toplardamarların genişlemesiyle ortaya çıkar ve sperm üretimini olumsuz etkileyebilir. WebMD’ye göre, varikosel ameliyatı, genişlemiş damarların bağlanmasıyla testislerdeki sıcaklığın düşmesini sağlayarak sperm üretimini iyileştirebilir. Dikkat edilmesi gereken varikoselin her zaman cerrahi tedavi gerektirmediğidir.
Bunun yanı sıra, sperm kanalında tıkanıklık veya doğuştan gelen yapısal sorunlar gibi cerrahi düzeltme gerektiren durumlar da ameliyatla tedavi edilebilir. Gelişen tıbbi teknolojiler sayesinde cerrahi tek çözüm değildir. Nitekim sperm toplama teknikleri kullanılabilir ve yardımcı üreme yöntemlerine başvurulabilir.
İlk gebelikten sonra yeniden hamile kalmak bazen beklenenden daha uzun sürebilir. Bu süreçte yalnızca kadına ya da erkeğe odaklanmak yerine, çiftin tüm sağlık öyküsünü birlikte değerlendirmek daha doğru bir yaklaşım sunar. İzmir’de ikincil infertilite nedenlerinin araştırılması ve size uygun tedavi seçeneklerinin planlanması için Doç. Dr. Funda Göde’den randevu alabilirsiniz.
Sık Sorulan Sorular
.jpg)
İçeriğimizin bu kısmında ikincil infertilite hakkında en çok merak edilenleri bulabilirsiniz.
Daha önce kolay hamile kaldım. Şimdi neden zorlaşıyor?
Bu durum şaşırtıcı görünse de sık karşılaşılır. Yaşın ilerlemesi, yumurta veya sperm kalitesindeki değişimler, enfeksiyonlar, kilo değişiklikleri, ameliyatlar, endometriozis, yumurtlama bozuklukları ya da yaşam tarzı etkenleri zaman içinde doğurganlığı etkileyebilir.
İkincil infertilite kadın kaynaklı mıdır?
Hayır. İnfertilite kadın kaynaklı, erkek kaynaklı, her iki partnere bağlı ya da açıklanamayan nedenlerle ilişkili olabilir. Bu yüzden değerlendirme çoğu zaman çift bazında yapılır. Tek tarafa odaklanmak süreci uzatabilir.
Sezaryen, rahim içi işlem ya da enfeksiyonlar sonradan etkili olabilir mi?
Evet, bazı durumlarda olabilir. Pelvik enfeksiyonlar, klamidya, gonore, PID, sezaryen ve bazı rahim içi işlemler sonrası gelişebilen skar dokusu veya tüp hasarı gebeliği zorlaştırabilir. Bu her işlemden sonra infertilite gelişeceği anlamına gelmez, risk kişiye ve oluşan hasarın derecesine göre değişir.
Kilo, sigara ve alkol gerçekten fark yaratır mı?
Evet, fark yaratabilir. WHO ve NHS; obezite, sigara ve aşırı alkol tüketiminin doğurganlık üzerinde olumsuz etkileri olabileceğini vurgular. NHS’ye göre fazla kilo doğurganlığı azaltabilir, sigara gebelik şansını düşürebilir ve semen kalitesini bozabilir.
Hiçbir neden bulunamazsa yine de tedavi planı yapılabilir mi?
Bazı olgularda neden saptanamayabilir. Bu durumda yaş, önceki öykü ve test sonuçları birlikte değerlendirilerek takip, yaşam tarzı düzenlemeleri ya da yardımcı üreme yöntemleri gibi seçenekler konuşulabilir. Nedenin net bulunmaması, her zaman hiçbir seçenek olmadığı anlamına gelmez.
Kaynaklar:
https://my.clevelandclinic.org/health/diseases/21139-secondary-infertility
https://www.webmd.com/infertility-and-reproduction/what-to-know-about-secondary-infertility
https://www.nhs.uk/conditions/infertility/
https://www.pennmedicine.org/conditions/secondary-infertility




